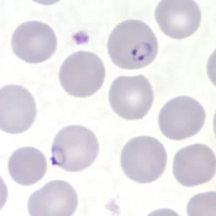
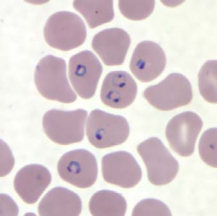
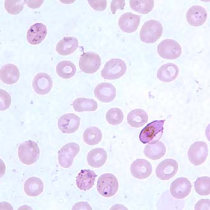
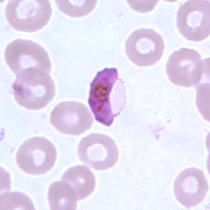
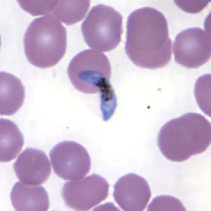
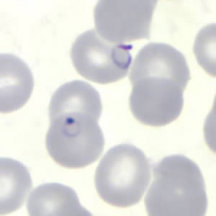
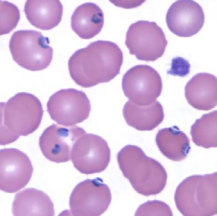
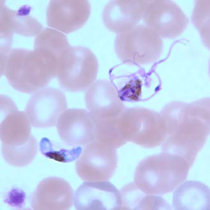
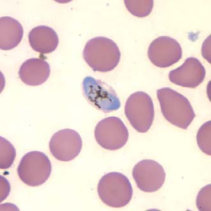

پلاسمودیوم فالسیپارم
اسپورداران
از ویژگیهای آن این است که گامتوسیتهای هلالی شکلی دارد. تروفوزوئیتهای رشد یافته (پیر)، مروزوئیتها و گامتوسیتهای نارس بندرت در خون محیطی دیده میشود. در لام خون محیطی بیماران آلوده به این نوع پلاسمودیوم معمولا فقط تروفوزوئیت جوان و گامتوسیتهای رسیده دیده میشوند.
راهنمایی های پایه:
- خون مویرگی باید از طریق سوراخ کردن نوک انگشت (فینگر استیک) یا خون وریدی از طریق خون گیری وریدی (ونیپانکچر) گرفته شود.
- اسمیرهای خونی، حداقل دو اسمیر ضخیم و دو اسمیر نازک، باید در سریعترین زمان ممکن پس از جمع آوری خون تهیه شوند. تاخیر در تهیه اسمیرها میتواند باعث ایجاد تغییر در مورفولوژی انگل و ویژگیهای رنگ آمیزی شود.
- نقاط شوفنر را میتوان با رنگ آمیزی گیمسا نشان داد که نسبت به رنگ آمیزی رایت یا رایت-گیمسا ارجحتر است.
در عفونتهای ناشی از پلاسمودیوم فالسیپاریوم، گلبولهای قرمز اندازهای طبیعی دارند. معمولا فقط فرمهای حلقوی و گامتوسیتهایشان دیده میشود، مگر اینکه خون قبل از تهیه اسمیر برای مدتی مانده باشد.
شکل حلقوی (رینگ فرم)
شکل حلقوی پلاسمودیوم فالسیپاریوم دارای سیتوپلاسم ظریف و یک یا دو نقطه کروماتینی کوچک است. گلبولهای قرمز آلوده بزرگ نمیشوند. در این گونه، آلودگی چندگانهی گلبولهای قرمز شایعتر از سایر گونههاست. گاهی فرمهای applique (حلقههایی که در حاشیه گلبول قرمز دیده میشوند) نیز وجود دارند.
گامتوسیت
گامتوسیتهای پلاسمودیوم فالسیپاریوم به شکل هلالی یا سوسیسی هستند . کروماتینشان بصورت یک توده منفرد (در کاروگامت) یا بصورت منتشر (در میکروگامت) دیده میشود.
تروفوزوئیت
تروفوزوئیتهای پلاسمودیوم فالسیپاریوم به ندرت در اسمیر خون محیطی مشاهده میشوند. انگلهای رینگی مسنتر، بعنوان تروفوزوئیت شناختع میشوند. سیتوپلاسم تروفوزوئیتهای بالغ متراکمتر از فرم رینگیشان است. هنگام رشد و بلوغ، تروفوزوئیتها معمول شکل حلقوی خود را حفظ کرده و گاهی مقادیر اندکی رنگدانه زرد در سیتوپلاسم آنها دیده میشود. تروفوزئیتهای در حال رشد ممکن است اندکی آمیبی شکل بنظر برسند.
شیزونت
شیزونتهای پلاسمودیوم فالسیپاریوم به ندرت در خون محیطی دیده میشوند. شیزونتهای بالغ دارای 8 الی 24 مروزوئیت کوچک هستند و رنگدانههای تیره دارند که بصورت یک توده متراکم تجمع یافتهاند.

 پلاسمودیوم فالسیپارم
پلاسمودیوم فالسیپارم
 پلاسمودیوم فالسیپارم
پلاسمودیوم فالسیپارم
 پلاسمودیوم فالسیپاروم تروفوزوئیت های حلقه ای شکل)
پلاسمودیوم فالسیپاروم تروفوزوئیت های حلقه ای شکل)
 پلاسمودیوم فالسیپاروم (گامتوسیت)
پلاسمودیوم فالسیپاروم (گامتوسیت)
 پلاسمودیوم فالسیپاروم تروفوزوئیت های حلقه ای شکل)
پلاسمودیوم فالسیپاروم تروفوزوئیت های حلقه ای شکل)
 پلاسمودیـوم فالسیپاروم (گـامتــوسیت - رنگ آمیزی گیمسا)
پلاسمودیـوم فالسیپاروم (گـامتــوسیت - رنگ آمیزی گیمسا)
 اووسیست های پلاسمودیوم روی دستگاه گوارش پشه
اووسیست های پلاسمودیوم روی دستگاه گوارش پشه
 رینگها در اسمیر خونی ضخیم
رینگها در اسمیر خونی ضخیم
 رینگها در اسمیر خونی ضخیم
رینگها در اسمیر خونی ضخیم
 رینگها در اسمیر خونی ضخیم – به شکل کلاسیک هدفون مانند رینگها توجه کنید.
رینگها در اسمیر خونی ضخیم – به شکل کلاسیک هدفون مانند رینگها توجه کنید.
رینگهای ظریف در یک اسمیر خونی نازک – به کروماتین دو نقطهای در گلبول قرمز آلوده در قسمت بالایی اسمیر و فرم applique در گلبول قرمز آلوده در قسمت پایینی توجه کنید.
رینگهای ظریف در یک اسمیر خونی نازک – به کروماتین دو نقطهای در گلبول قرمز آلوده در قسمت بالایی اسمیر و فرم applique در گلبول قرمز آلوده در قسمت پایینی توجه کنید.
 رینگها در یک اسمیر خونی – به چندین گلبول قرمز آلوده شده توجه کنید.
رینگها در یک اسمیر خونی – به چندین گلبول قرمز آلوده شده توجه کنید.
رینگها در یک اسمیر خونی نازک - به چندین گلبول قرمز آلوده شده توجه کنید، بعضی دارای فرم applique هستند و بعضی فرم کلاسیک هدفون مانند را دارند.
رینگها در یک اسمیر خونی نازک - به چندین گلبول قرمز آلوده شده توجه کنید، بعضی دارای فرم applique هستند و بعضی فرم کلاسیک هدفون مانند را دارند.
 رینگها و تعدادی تروفوزوئیت در حال تشکیل در این اسمیرها قابل رویت است – به شکافهای غشایی Maurer که گاهی در رینگهای قدیمیتر دیده میشود دقت کنید. شکافهای Maurer در pH قلیایی 7.2 الی 7.6 بهتر رنگ میپذیرند.
رینگها و تعدادی تروفوزوئیت در حال تشکیل در این اسمیرها قابل رویت است – به شکافهای غشایی Maurer که گاهی در رینگهای قدیمیتر دیده میشود دقت کنید. شکافهای Maurer در pH قلیایی 7.2 الی 7.6 بهتر رنگ میپذیرند.
 رینگها و تعدادی تروفوزوئیت در حال تشکیل در این اسمیرها قابل رویت است – به شکافهای غشایی Maurer که گاهی در رینگهای قدیمیتر دیده میشود دقت کنید. شکافهای Maurer در pH قلیایی 7.2 الی 7.6 بهتر رنگ میپذیرند.
رینگها و تعدادی تروفوزوئیت در حال تشکیل در این اسمیرها قابل رویت است – به شکافهای غشایی Maurer که گاهی در رینگهای قدیمیتر دیده میشود دقت کنید. شکافهای Maurer در pH قلیایی 7.2 الی 7.6 بهتر رنگ میپذیرند.
 گامتوسیت در اسمیر خونی ضخیم – همچنین به حضور تعداد زیادی رینگ دقت کنید.
گامتوسیت در اسمیر خونی ضخیم – همچنین به حضور تعداد زیادی رینگ دقت کنید.
گامتوسیت در اسمیر خونی نازک به همراه رینگها و شکافهای Maurer
گامتوسیت در اسمیر خونی نازک به همراه رینگها و شکافهای Maurer
گامتوسیت در اسمیر خونی نازک – غشای گلبول قرمز در این اسمیر قابل رویت است.
گامتوسیت در اسمیر خونی نازک – غشای گلبول قرمز در این اسمیر قابل رویت است.
گامتوسیتها در اسمیر خونی نازک – به حضور "Laveran's bib" دقت کنید (همیشه قابل رویت نمیباشد).
گامتوسیتها در اسمیر خونی نازک – به حضور "Laveran's bib" دقت کنید (همیشه قابل رویت نمیباشد).
 تروفوزوئیتها در اسمیر خونی ضخیم
تروفوزوئیتها در اسمیر خونی ضخیم
 تروفوزوئیتهای فشرده در اسمیر خونی نازک
تروفوزوئیتهای فشرده در اسمیر خونی نازک
 شیزونت پاره شده در اسمیر خونی نازک
شیزونت پاره شده در اسمیر خونی نازک
 پلاسمودیوم فالسیپارم
پلاسمودیوم فالسیپارم
 گامتوسیت فالسیپاروم
گامتوسیت فالسیپاروم
 پلاسمودیوم فالسیپاروم تروفوزوئیت های حلقه ای شکل)
پلاسمودیوم فالسیپاروم تروفوزوئیت های حلقه ای شکل)
 پلاسمودیوم فالسیپاروم تروفوزوئیت های حلقه ای شکل)
پلاسمودیوم فالسیپاروم تروفوزوئیت های حلقه ای شکل)
 پلاسمودیوم فالسیپاروم تروفوزوئیت های حلقه ای شکل)
پلاسمودیوم فالسیپاروم تروفوزوئیت های حلقه ای شکل)
 اسپوروزوئیت پلاسمودیوم
اسپوروزوئیت پلاسمودیوم
 مرحله نسجی پلاسمودیوم در بافت کبد
مرحله نسجی پلاسمودیوم در بافت کبد
 رینگها در اسمیر خونی ضخیم
رینگها در اسمیر خونی ضخیم
 رینگها در اسمیر خونی ضخیم
رینگها در اسمیر خونی ضخیم
 رینگها در اسمیر خونی ضخیم – به شکل کلاسیک هدفون مانند رینگها توجه کنید.
رینگها در اسمیر خونی ضخیم – به شکل کلاسیک هدفون مانند رینگها توجه کنید.
رینگهای ظریف در یک اسمیر خونی نازک
رینگهای ظریف در یک اسمیر خونی نازک
رینگها در یک اسمیر خونی نازک - به چندین گلبول قرمز آلوده شده توجه کنید، بعضی دارای فرم applique هستند و بعضی فرم کلاسیک هدفون مانند را دارند.
رینگها در یک اسمیر خونی نازک - به چندین گلبول قرمز آلوده شده توجه کنید، بعضی دارای فرم applique هستند و بعضی فرم کلاسیک هدفون مانند را دارند.
 رینگها در یک اسمیر خونی نازک - به چندین گلبول قرمز آلوده شده توجه کنید، بعضی دارای فرم applique هستند و بعضی فرم کلاسیک هدفون مانند را دارند.
رینگها در یک اسمیر خونی نازک - به چندین گلبول قرمز آلوده شده توجه کنید، بعضی دارای فرم applique هستند و بعضی فرم کلاسیک هدفون مانند را دارند.
 رینگها و تعدادی تروفوزوئیت در حال تشکیل در این اسمیرها قابل رویت است – به شکافهای غشایی Maurer که گاهی در رینگهای قدیمیتر دیده میشود دقت کنید. شکافهای Maurer در pH قلیایی 7.2 الی 7.6 بهتر رنگ میپذیرند.
رینگها و تعدادی تروفوزوئیت در حال تشکیل در این اسمیرها قابل رویت است – به شکافهای غشایی Maurer که گاهی در رینگهای قدیمیتر دیده میشود دقت کنید. شکافهای Maurer در pH قلیایی 7.2 الی 7.6 بهتر رنگ میپذیرند.
 گامتوسیت در اسمیر خونی ضخیم
گامتوسیت در اسمیر خونی ضخیم
 گامتوسیت در اسمیر خونی ضخیم – همچنین به حضور تعداد زیادی رینگ دقت کنید.
گامتوسیت در اسمیر خونی ضخیم – همچنین به حضور تعداد زیادی رینگ دقت کنید.
 دو گامتوسیت در اسمیر خونی نازک
دو گامتوسیت در اسمیر خونی نازک
گامتوسیتها؛ گامتوسیت موجود در سمت راست در فرایند exflagellation هستند.
گامتوسیتها؛ گامتوسیت موجود در سمت راست در فرایند exflagellation هستند.
گامتوسیتها در اسمیر خونی نازک – به حضور "Laveran's bib" دقت کنید (همیشه قابل رویت نمیباشد).
گامتوسیتها در اسمیر خونی نازک – به حضور "Laveran's bib" دقت کنید (همیشه قابل رویت نمیباشد).
 تروفوزوئیتهای بالغ و فشرده در اسمیر خونی نازک
تروفوزوئیتهای بالغ و فشرده در اسمیر خونی نازک
 شیزونت بالغ در اسمیر خونی نازک
شیزونت بالغ در اسمیر خونی نازک
 شیزونت در اسمیر خونی نازک
شیزونت در اسمیر خونی نازک